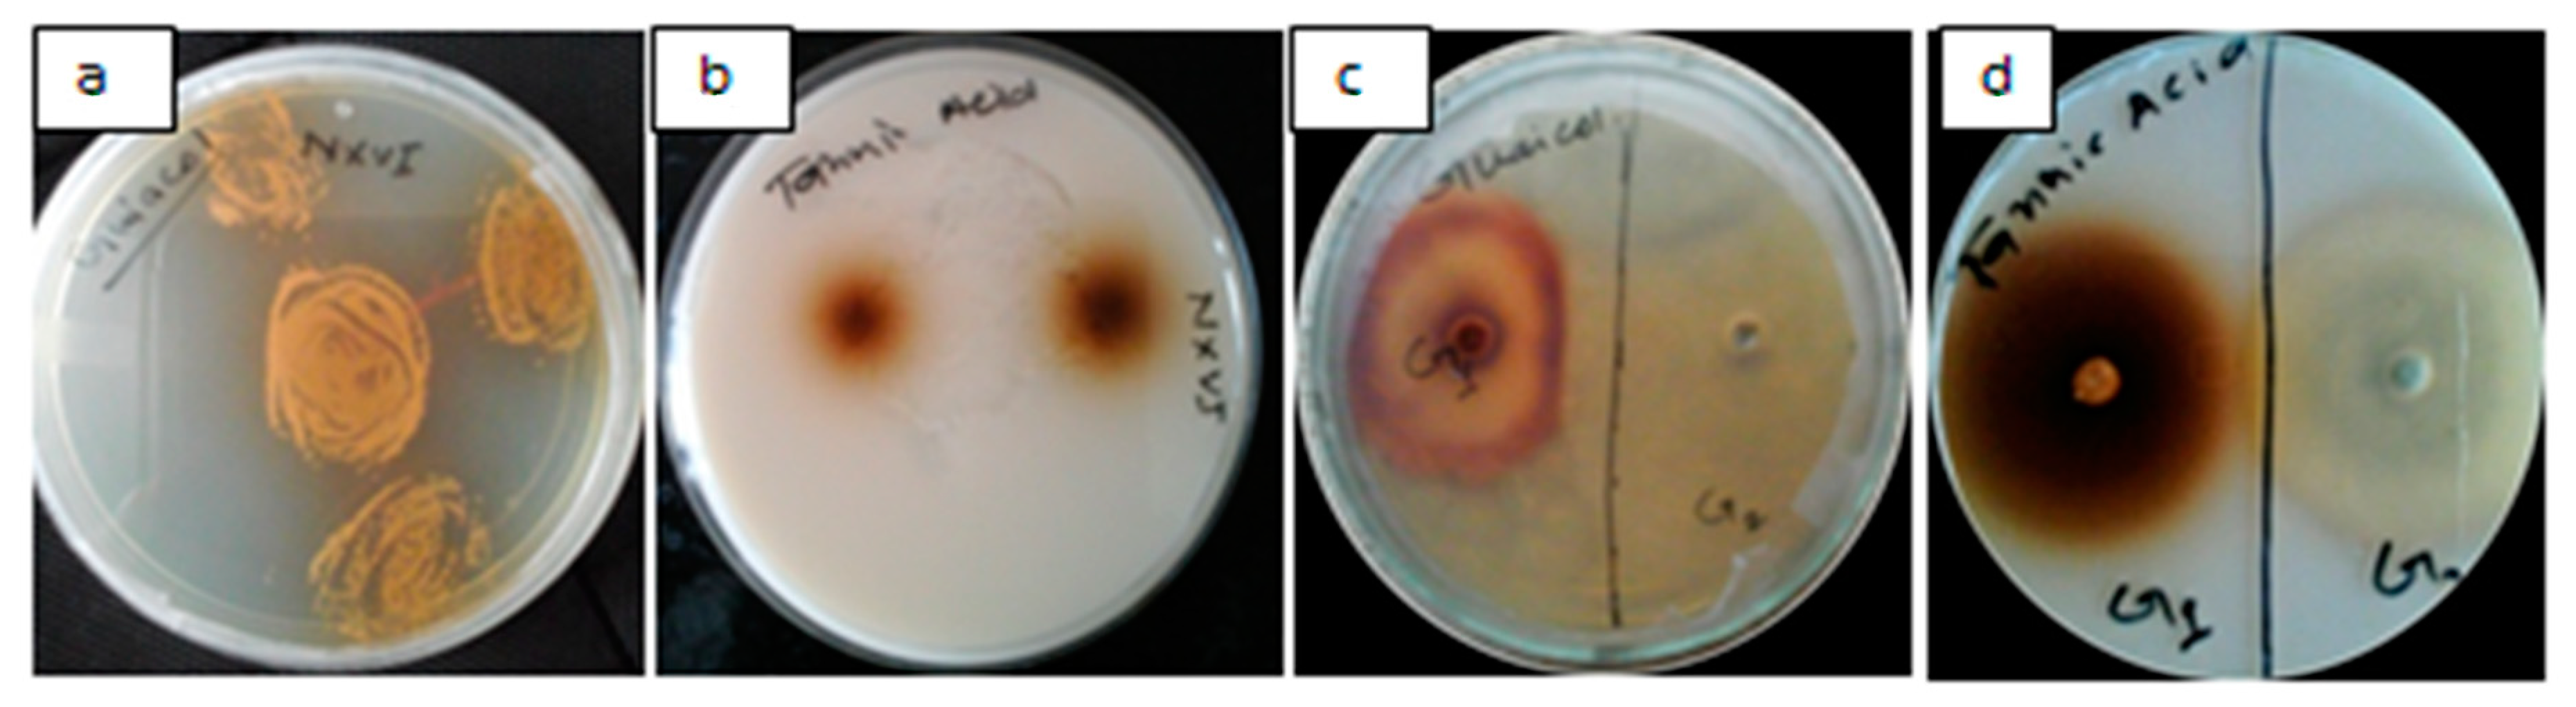
Applsci 09 00340 g001 Applsci 09 00340 g001

Secretory Laccase from Pestalotiopsis Species CDBT-F-G1 Fungal Strain Isolated from High Altitude: Optimization of Its Production and Characterization
Abstract
1. Introduction
2. Materials and Methods
2.1. Materials
2.2. Sample Collection
2.3. Isolation, Screening, and Identification of Laccase-Producing Microbes
2.3.1. Isolation and Screening of Microbial Species for Laccase Production
2.3.2. Isolation of Genomic DNA (gDNA)
2.3.3. PCR Amplification of 18S rRNA and Sequencing
2.3.4. Optimization of Laccase Production
2.4. Determination of Laccase Activity
2.5. Isolation and Partial Characterization of Laccase
2.5.1. Enrichment of Laccase
2.5.2. Protein Concentration Determination
2.5.3. SDS Gel Electrophoresis
2.5.4. Characterization of Laccase
2.6. Data Analysis
3. Results
3.1. Isolation and Screening of Laccase-Producing Microbes
3.2. Morphology of CDBT-F-G1 Fungal Isolate
3.3. Extraction of gDNA from CDBT-F-G1 Isolate and PCR Amplification of 18s RNA Gene
3.4. Production Media Optimization for Laccase Production
3.4.1. Effect of pH
3.4.2. Effect of Temperature
3.4.3. Effects of Metal Ions on Laccase Production
3.4.4. Effect of Agitation
3.4.5. Effects of Surfactant on Laccase Production
3.4.6. Effect of Dissolved Oxygen (DO)
3.4.7. Effects of Inducers and Inhibitors
3.5. Partial Purification of Laccase from Fermentation Broth
3.6. Characterization of Partially Purified Laccase
3.6.1. Temperature Optima and Thermal Stability
3.6.2. Optimum pH and pH Stability
3.6.3. SDS-PAGE Analysis
3.6.4. Kinetic Constants
4. Discussion
5. Conclusions
Author Contributions
Acknowledgments
Conflicts of Interest
References
- Baldrian, P. Fungal laccases–occurrence and properties. FEMS Microbiol. Rev. 2016, 30, 215–242. [Google Scholar] [CrossRef]
- Wesenberg, D.; Kyriakides, I.; Agathos, S.N. White-rot fungi and their enzymes for the treatment of industrial dye effluents. Biotechnol. Adv. 2003, 22, 161–187. [Google Scholar] [CrossRef]
- Bourbonnais, R.; Paice, M.; Reid, I.; Lanthier, P.; Yaguchi, M. Lignin oxidation by laccase isozymes from Trametes versicolor and role of the mediator 2,2’-azinobis (3-ethylbenzthiazoline-6-sulfonate) in kraft lignin depolymerization. Appl. Environ. Microbiol. 1995, 61, 1876–1880. [Google Scholar]
- Sharma, A.; Aggarwal, N.; Yadav, A. Isolation and Screening of Lignolytic Fungi from Various Ecological Niches. Univ. J. Microbiol. Res. 2017, 5, 25–34. [Google Scholar]
- Robinson, T.; Chandran, B.; Nigam, P. Studies on the production of enzymes by white-rot fungi for the decolourisation of textile dyes. Enzym. Microb. Technol. 2001, 29, 575–579. [Google Scholar] [CrossRef]
- Subramanian, J.; Ramesh, T.; Kalaiselvam, M. Fungal Laccases—Properties and Applications: A Review. Int. J. Pharm. Boil. Arch. 2014, 5, 8–16. [Google Scholar]
- Verma, S.R.; Dwivedi, U.N. Lignin genetic engineering for improvement of wood quality: Applications in paper and textile industries, fodder and bioenergy production. S. Afr. J. Bot. 2014, 91, 107–125. [Google Scholar]
- Williams, S.T.; Davies, F.L. Use of antibiotics for selective isolation and enumeration of Actinomycetes in soil. J. Gen. Microbiol. 1965, 38, 251–261. [Google Scholar] [CrossRef]
- Aljanabi, S.M.; Martinez, I. Universal and rapid salt-extraction of high quality genomic DNA for PCR-based techniques. Nucleic Acids Res. 1997, 25, 4692–4693. [Google Scholar] [CrossRef]
- Rajesh, K.; Dhanasekaran, D.; Panneerselvam, A. Isolation and taxonomic characterization of medicinal mushroom Ganoderma spp. Acad. J. Microbiol. Res. 2014, 2, 61–70. [Google Scholar]
- More, S.S.; P.S., R.; K., P.; Malini, S.; S.M., V. Isolation, Purification, and Characterization of Fungal Laccase from Pleurotus sp. Enzyme Res. 2011, 2011, 248735. [Google Scholar]
- Li, A.; Zhu, Y.; Xu, L.; Zhu, W.; Tian, X. Comparative study on the determination of assay for laccase of Trametes sp. Afr. J. Biochem. Res. 2008, 2, 181–183. [Google Scholar]
- Han, M.J.; Han, M.; Choi, H.; Song, H. Purification and characterization of laccase from the white rot fungus Trametes versicolor. J. Microbiol. 2006, 43, 555–560. [Google Scholar]
- Bryjak, J.; Rekuć, A. Effective purification of Cerrena unicolor laccase using microfiltration, ultrafiltration and acetone precipitation. Appl. Biochem. Biotechnol. 2010, 160, 2219–2235. [Google Scholar] [CrossRef] [PubMed]
- Bradford, M.M. A rapid and sensitive method for the quantitation of microgram quantities of protein utilizing the principle of protein-dye binding. Anal. Biochem. 1976, 72, 248–254. [Google Scholar] [CrossRef]
- Hildén, K.; Hakala, T.; Maijala, P.; Lundell, T.; Hatakka, A. Novel thermotolerant laccases produced by the white-rot fungus Physisporinus rivulosa. Appl. Microbiol. Biotechnol. 2007, 7, 301–309. [Google Scholar] [CrossRef] [PubMed]
- Kiiskinen, L.L.; Ratto, M.; Kruus, K. Screening for novel laccase-producing microbes. J. Appl. Microbiol. 2004, 97, 640–646. [Google Scholar] [CrossRef] [PubMed]
- Shrestha, P.; Joshi, B.; Joshi, J.; Malla, R.; Sreerama, L. Isolation and Physicochemical Characterization of Laccase from Ganoderma lucidum-CDBT1 Isolated from Its Native Habitat in Nepal. BioMed Res. Int. 2016, 2016, 3238909. [Google Scholar] [CrossRef]
- Lazarotto, M.; Bovolini, M.P.; Muniz, M.F.B.; Harakawa, R.; Reiniger, L.R.S.; Santos, Á.F. Identification and characterization of pathogenic Pestalotiopsis species to pecan tree in Brazil. Pesq. Agropec. Brasil. 2014, 49, 440–448. [Google Scholar] [CrossRef]
- Aly, A.H.; Debbab, A.; Kjer, J.; Proksch, P. Fungal endophytes from higher plants: A prolific source of phytochemicals and other bioactive natural products. Fungal Divers. 2010, 41, 1–16. [Google Scholar] [CrossRef]
- Ko, E.M.; Leem, Y.E.; Choi, H.T. Purification and characterization of laccase isozymes from the white-rot basidiomycete Ganoderma lucidum. Appl. Microbiol. Biotechnol. 2001, 57, 98–102. [Google Scholar] [PubMed]
- Palmieri, G.; Giardina, P.; Bianco, C.; Fontanella, B.; Sannia, G. Copper induction of laccase isoenzymes in the ligninolytic fungus Pleurotus ostreatus. Appl. Environ. Microbiol. 2000, 66, 920–924. [Google Scholar] [CrossRef] [PubMed]
- Wuyep, P.A.; Khan, A.U.; Nok, A.J. Production and regulation of lignin degrading enzymes from Lentinus squarrosulus (mont.) Singer and Psathyrella atroumbonata Pegler. Afr. J. Biotechnol. 2003, 2, 444–447. [Google Scholar]
- Sathiya, M.; Periyar, S.; Sasikalaveni, A.; Murugesan, K.; Kalaichelvan, P.T. Decolorization of textile dyes and their effluents using white rot fungi. Afr. J. Biotechnol. 2007, 6, 424–429. [Google Scholar]
- Tavares, A.P.M.; Coelho, M.A.Z.; Coutinho, J.A.P.; Xavier, A.M.R.B. Laccase improvement in submerged cultivation: Induced production and kinetic modelling. J. Chem. Technol. Biotechnol. 2005, 80, 669–676. [Google Scholar] [CrossRef]
- Arfi, Y.; Chevret, D.; Henrissat, B.; Berrin, J.G.; Levasseur, A.; Record, E. Characterization of salt-adapted secreted lignocellulolytic enzymes from the mangrove fungus Pestalotiopsis sp. Nat. Commun. 2013, 4, 1810. [Google Scholar] [CrossRef]
- Martina, M.; Jožefa, F.; Aleksander, P. Decoloration of the diazo dye reactive black by immolized Bjerkandera adusta in a stirred tank bioreactor. Acta Chim. Slov. 2004, 51, 619–628. [Google Scholar]
- Zheng, Z.; Obbard, J.P. Oxidation of polycyclic aromatic hydrocarbons by fungal isolates from an oil contaminated refinery soil. Environ. Sci. Pollut. Res. 2003, 10, 173–176. [Google Scholar] [CrossRef]
- Wong, D.W. Structure and Action Mechanism of Ligninolytic Enzymes. Appl. Biochem. Biotechnol. 2008, 157, 174–209. [Google Scholar] [CrossRef] [PubMed]
- Ikehata, K.; El-Din, M.G. Degradation of Recalcitrant Surfactants in Wastewater by Ozonation and Advanced Oxidation Processes: A Review. Ozone Sci. Eng. 2004, 26, 327–343. [Google Scholar] [CrossRef]
- Bollag, J.M.; Leonowicz, A. Comparative studies of extracellular fungal laccases. Appl. Environ. Microbiol. 1984, 48, 849–854. [Google Scholar] [PubMed]
- Nadeem, A.; Baig, S.; Sheikh, N. Mycotechnological production of laccase by Pleurotus ostreatus-P1 and its inhibition study. J. Anim. Plant Sci. 2014, 24, 492–502. [Google Scholar]
- Faraco, V.; Giardina, P.; Palmieri, G.; Sannia, G. Metal-activated laccase promoters. Prog. Biotechnol. 2002, 21, 105–111. [Google Scholar]
- Hao, J.; Song, F.; Huang, F.; Yang, C.; Zhang, Z.; Zheng, Y.; Tian, X. Production of laccase by a newly isolated deuteromycete fungus Pestalotiopsis sp. and its decolorization of azo dye. J. Ind. Microbiol. Biotechnol. 2007, 34, 233–240. [Google Scholar]
- Rehman, A.U.; Thurston, C.F. Purification of laccase I from Armillaria mellea. J. Gen. Microbiol. 1992, 138, 1251–1257. [Google Scholar] [CrossRef]
- Vivekanandan, K.E.; Sivaraj, S.; Kumaresan, S. Characterization and purification of laccase enzyme from Aspergillus nidulans CASVK3 from vellar estuary south east coast of India. Int. J. Curr. Microbiol. App. Sci. 2014, 3, 213–227. [Google Scholar]
- Marques De Souza, C.G.; Peralta, R.M. Purification and characterization of the main laccase produced by the white-rot fungus Pleurotus pulmonarius on wheat bran solid state medium. J. Basic Microbiol. 2003, 43, 278–286. [Google Scholar]
- Rastogi, A.; Singh, P. Partial Purification and Characterization of Laccase Enzyme Isolated From Carpet and Textile Effluent. IOSR J. Biotechnol. Biochem. 2017, 3, 43–51. [Google Scholar]
- Tapia-Tussell, R.; Pérez-Brito, D.; Torres-Calzada, C.; Cortés-Velázque, A.; Alzate-Gaviria, L.; Chablé-Villacís, R.; Solís-Pereira, S. Laccase Gene Expression and Vinasse Biodegradation by Trametes hirsuta Strain Bm-2. Molecules 2015, 20, 15147–15157. [Google Scholar] [CrossRef]
- Sun, S.J.; Zhang, Y.H.; Que, Y.X.; Liu, B.X.; Hu, K.H.; Xu, L.P. Purification and Characterization of Fungal Laccase from Mycena purpureofusca. Chiang Mai J. Sci. 2013, 40, 151–160. [Google Scholar]

| S.N. | Sample Code | Type of Species | Guaiacol | Tannic Acid | 1-Napthol |
|---|---|---|---|---|---|
| 1 | CDBT-A-3 | Actinomycetes | + | ++ | +/− |
| 2 | CDBT-A-5 | Actinomycetes | + | ++ | +/− |
| 3 | CDBT-S-6 | Streptomycetes | + | ++ | +/− |
| 4 | CDBT-S-7 | Streptomycetes | + | ++ | +/− |
| 5 | CDBT-S-10 | Streptomycetes | + | ++ | +/− |
| 6 | CDBT-S-11 | Streptomycetes | + | ++ | +/− |
| 7 | CDBT-S-13 | Streptomycetes | +++ | + | +/− |
| 8 | CDBT-S-14 | Streptomycetes | + | ++ | +/− |
| 9 | CDBT-S-16 | Streptomycetes | ++ | +++ | +/− |
| 10 | CDBT-F-G1 | Fungi | +++++ | +++++ | +/− |
| 11 | CDBT-F-G2 | Fungi | + | + | +/− |
| 12 | CDBT-F-G3 | Fungi | + | + | +/− |
| Fraction Analyzed | Activity (U/mL) | Protein (µg/mL) | Specific Activity (U/mg) | Fold Purification | % Recovery |
|---|---|---|---|---|---|
| Culture media filtrate | 69.2 | 184 | 377 | 1.0 | 100 |
| Ammonium sulfate fraction (40–70%) | 882 | 33.6 | 26,200 | 13 | 69 |
| Acetone precipitate (1:5 volume fraction) | 957 | 30.1 | 31,700 | 14 | 84 |
© 2019 by the authors. Licensee MDPI, Basel, Switzerland. This article is an open access article distributed under the terms and conditions of the Creative Commons Attribution (CC BY) license (http://creativecommons.org/licenses/by/4.0/).
Share and Cite
Yadav, M.; Bista, G.; Maharjan, R.; Poudyal, P.; Mainali, M.; Sreerama, L.; Joshi, J. Secretory Laccase from Pestalotiopsis Species CDBT-F-G1 Fungal Strain Isolated from High Altitude: Optimization of Its Production and Characterization. Appl. Sci. 2019, 9, 340. https://doi.org/10.3390/app9020340
Yadav M, Bista G, Maharjan R, Poudyal P, Mainali M, Sreerama L, Joshi J. Secretory Laccase from Pestalotiopsis Species CDBT-F-G1 Fungal Strain Isolated from High Altitude: Optimization of Its Production and Characterization. Applied Sciences. 2019; 9(2):340. https://doi.org/10.3390/app9020340
Chicago/Turabian StyleYadav, Mukesh, Garima Bista, Rocky Maharjan, Pranita Poudyal, Milan Mainali, Lakshmaiah Sreerama, and Jarina Joshi. 2019. "Secretory Laccase from Pestalotiopsis Species CDBT-F-G1 Fungal Strain Isolated from High Altitude: Optimization of Its Production and Characterization" Applied Sciences 9, no. 2: 340. https://doi.org/10.3390/app9020340
APA StyleYadav, M., Bista, G., Maharjan, R., Poudyal, P., Mainali, M., Sreerama, L., & Joshi, J. (2019). Secretory Laccase from Pestalotiopsis Species CDBT-F-G1 Fungal Strain Isolated from High Altitude: Optimization of Its Production and Characterization. Applied Sciences, 9(2), 340. https://doi.org/10.3390/app9020340
